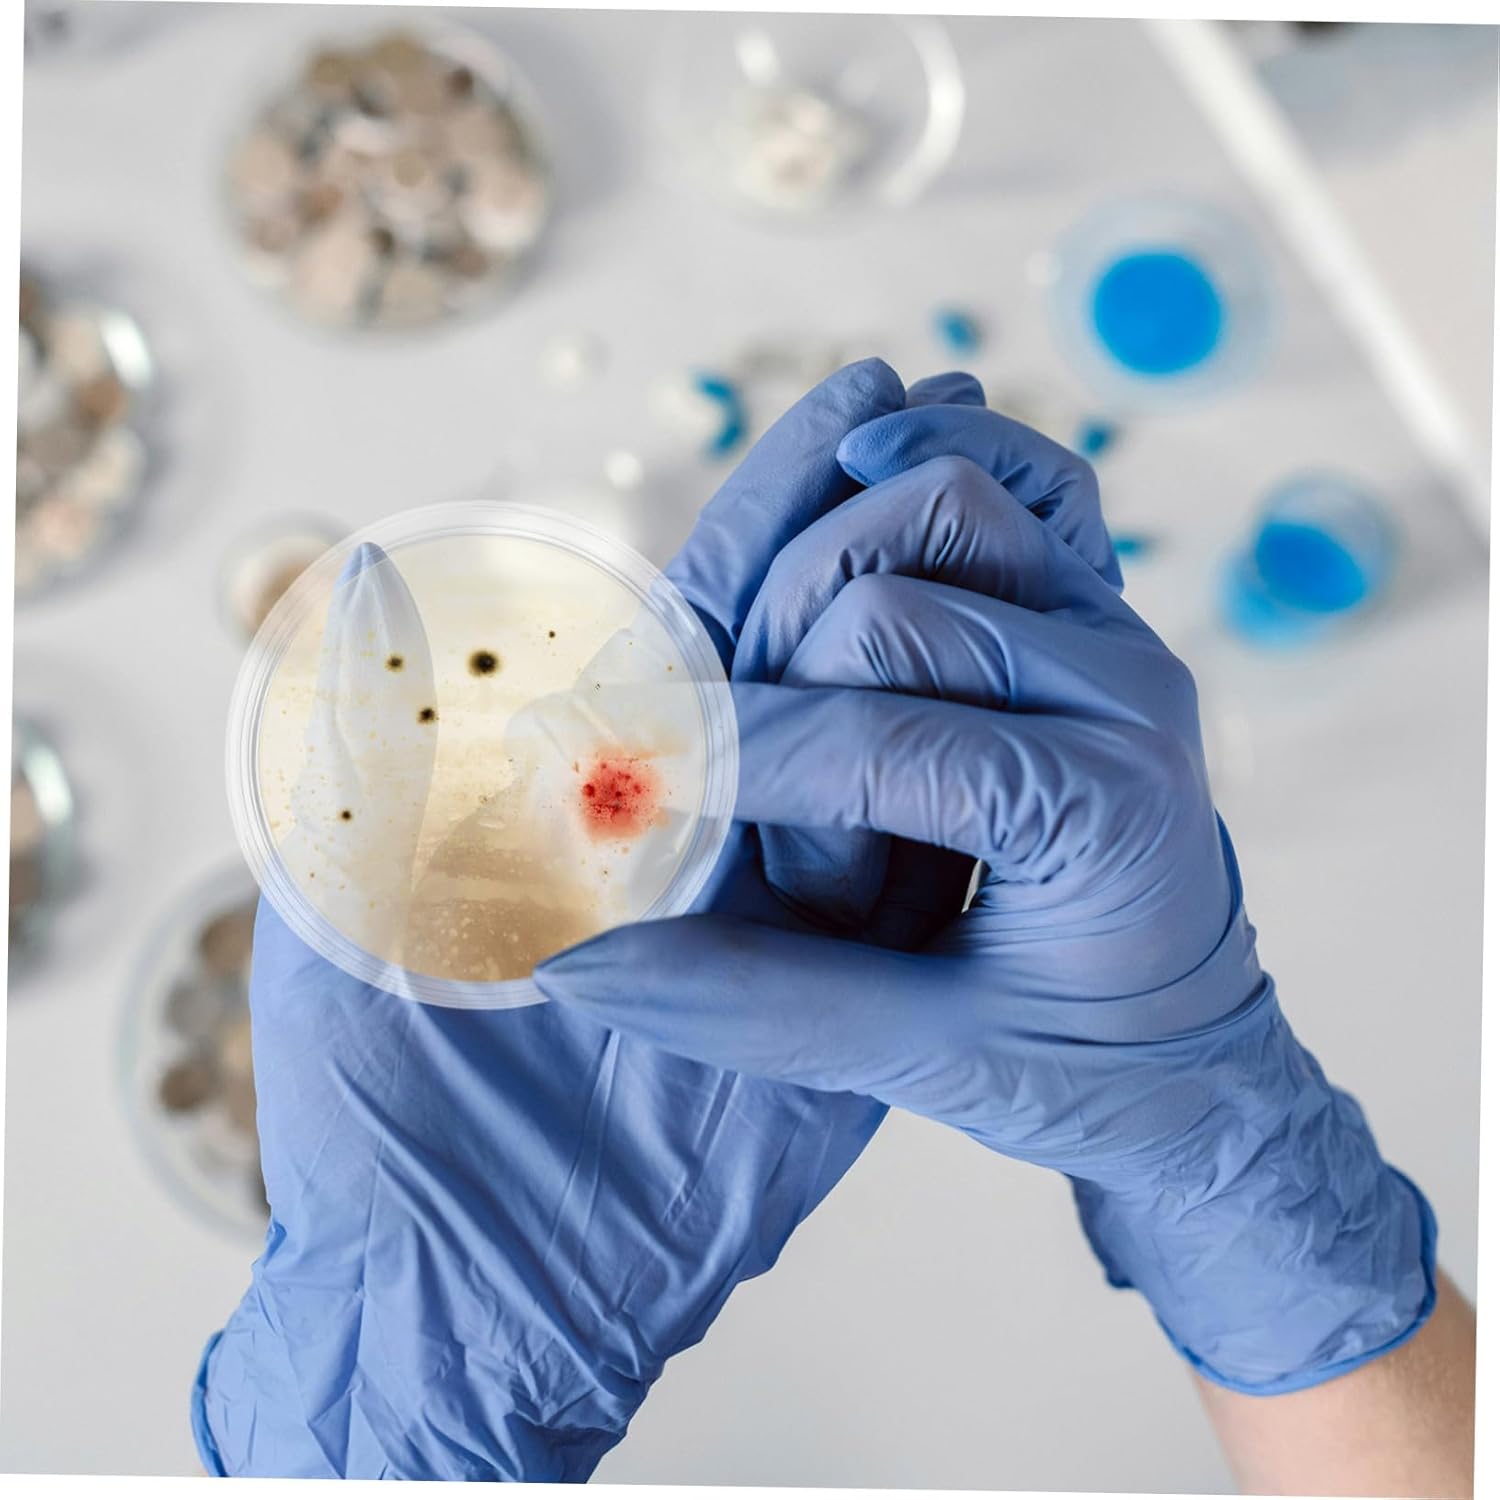
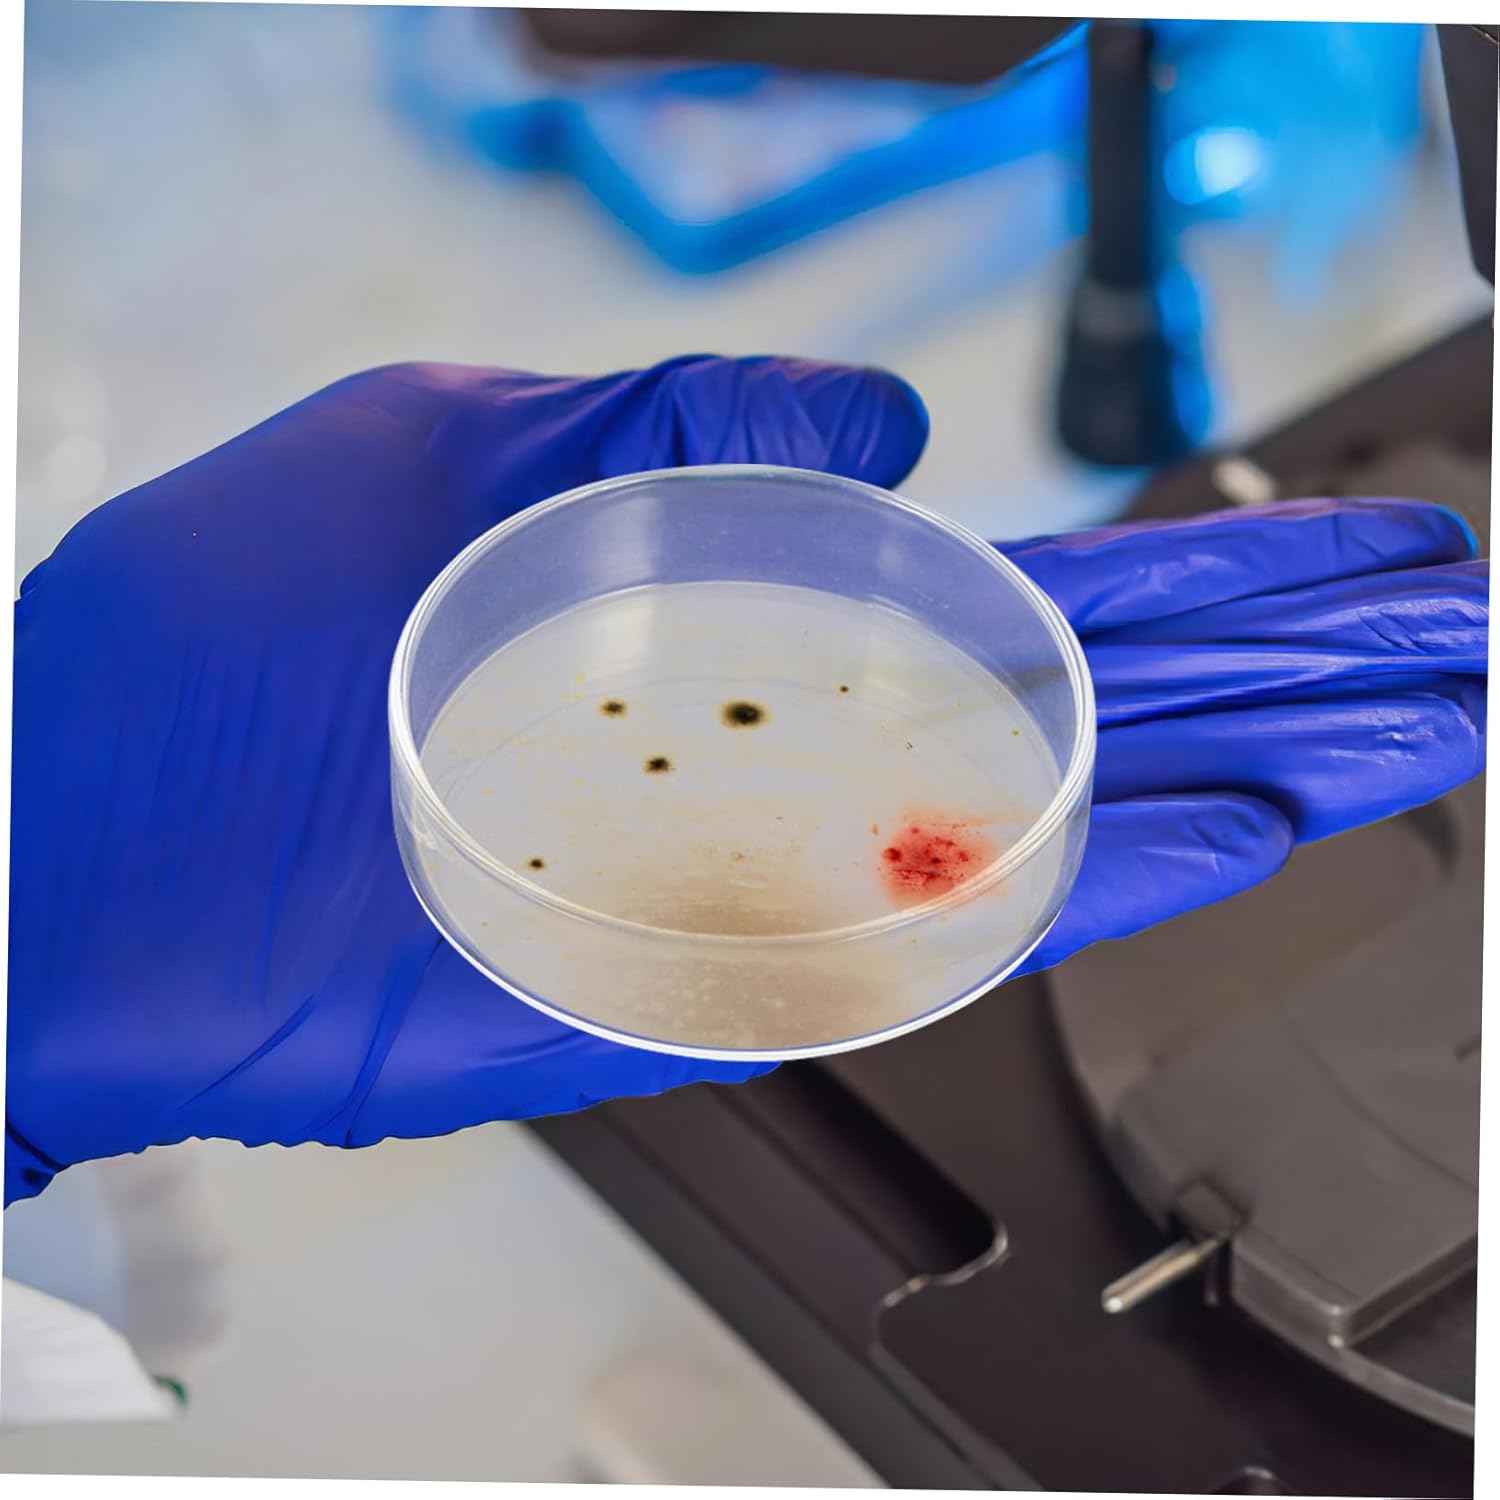

10pcs High Clarity Petri Plates Cell Culture Dishes for Lab Use Growth Educational Training Kits Microscopy Accessory
 Limited Time Sale
Limited Time Sale$20.15 cheaper than the new price!!
Free cash-on-delivery fees for purchases over $99
Product details
| Management number | 211046850 | Release Date | 2026/04/04 | List Price | $13.44 | Model Number | 211046850 | ||
|---|---|---|---|---|---|---|---|---|---|
| Category | |||||||||
Package List 10 x glass petri dishes Characteristics -Educational value: great for laboratory training, science experiments, and themed parties, these dishes offer a wide range of educational petri dishes - Color: Transparent glass petri dishes -Detailed microscopy: the optical clarity of these plates ensures precise and detailed observations during microscopic examinations, essential for accurate research culture dish -Size:9.80X9.80X2.20cm/3.85X3.85X0.86in science plates -Uniform cell : featuring a flat, smooth surface, these dishes promote even cell without clumping, and the vented lids ensure proper ventilation and protection culture plate - material: made from borosilicate glass, these culture dishes are reusable and can withstand temperatures, ensuring durability petri dish -Clear observation: the bubblefree, highclarity glass allows for easy and accurate observation of samples under a microscope, ideal for cultures agar plates -Material:Glass petri dishGoods Informationagar petri dishes The 90mm size is great for a variety of laboratory , providing ample space for and easy observation of samples.science lab equipment The glass ensures a environment for cell and cultures.science plates These laboratory culture dishes are designed to meet the needs of scientists and researchers
- Consistent cell growth: designed with a flat, smooth surface, these dishes promote uniform cell growth without clumping, and the vented lids ensure proper ventilation and protection,culture dish,petri plates
- Clear microscopy: the optical clarity of these plates ensures precise and detailed observations during microscopic examinations, crucial for accurate research,plates for laboratory use,petri dishes with lids
- High clarity: the clear, bubblefree glass allows for precise observation of samples under a microscope, making it ideal for mycological studies,science plates,glass petri dishes
- Glass: made fromborosilicate glass, these culture dishes are reusable and resistant to temperatures, providing durability for various lab , culture plate,lab petri dishes
- Enhanced visibility: the clear, bubblefree glass allows for easy and accurate observation of samples under a microscope, making it ideal for mycological studies, petri dishes, petri dish
| Department | Unisex Adult |
|---|---|
| Item Weight | 1.92 pounds |
| Manufacturer | PLAFOPE |
| Item model number | EVJ1210DR11R31MAMT |
| Product Dimensions | 3.86 x 3.86 x 0.87 inches |
Correction of product information
If you notice any omissions or errors in the product information on this page, please use the correction request form below.
Correction Request Form